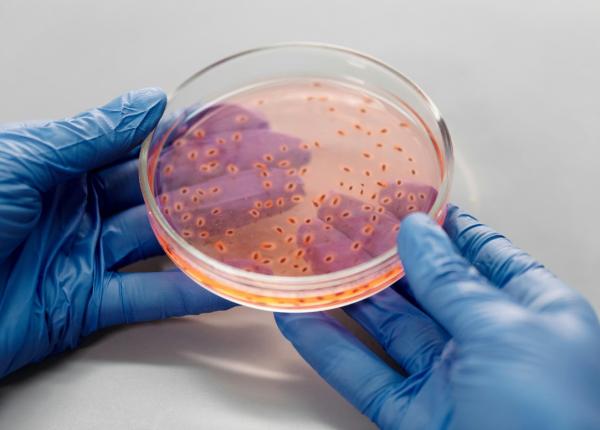
vitamina k%e2%82%82 din bacterii descoperirea care poate revolutiona nutritia

6 indicatori ai sănătății metabolice pe care ar trebui să îi ai în vedere
03 noi 2025
Expresia „nu judeca o carte după copertă” se potrivește perfect atunci când vorbim despre sănătatea metabolică. Deși, în trecut, mulți specialiști considerau greutatea corporală și...